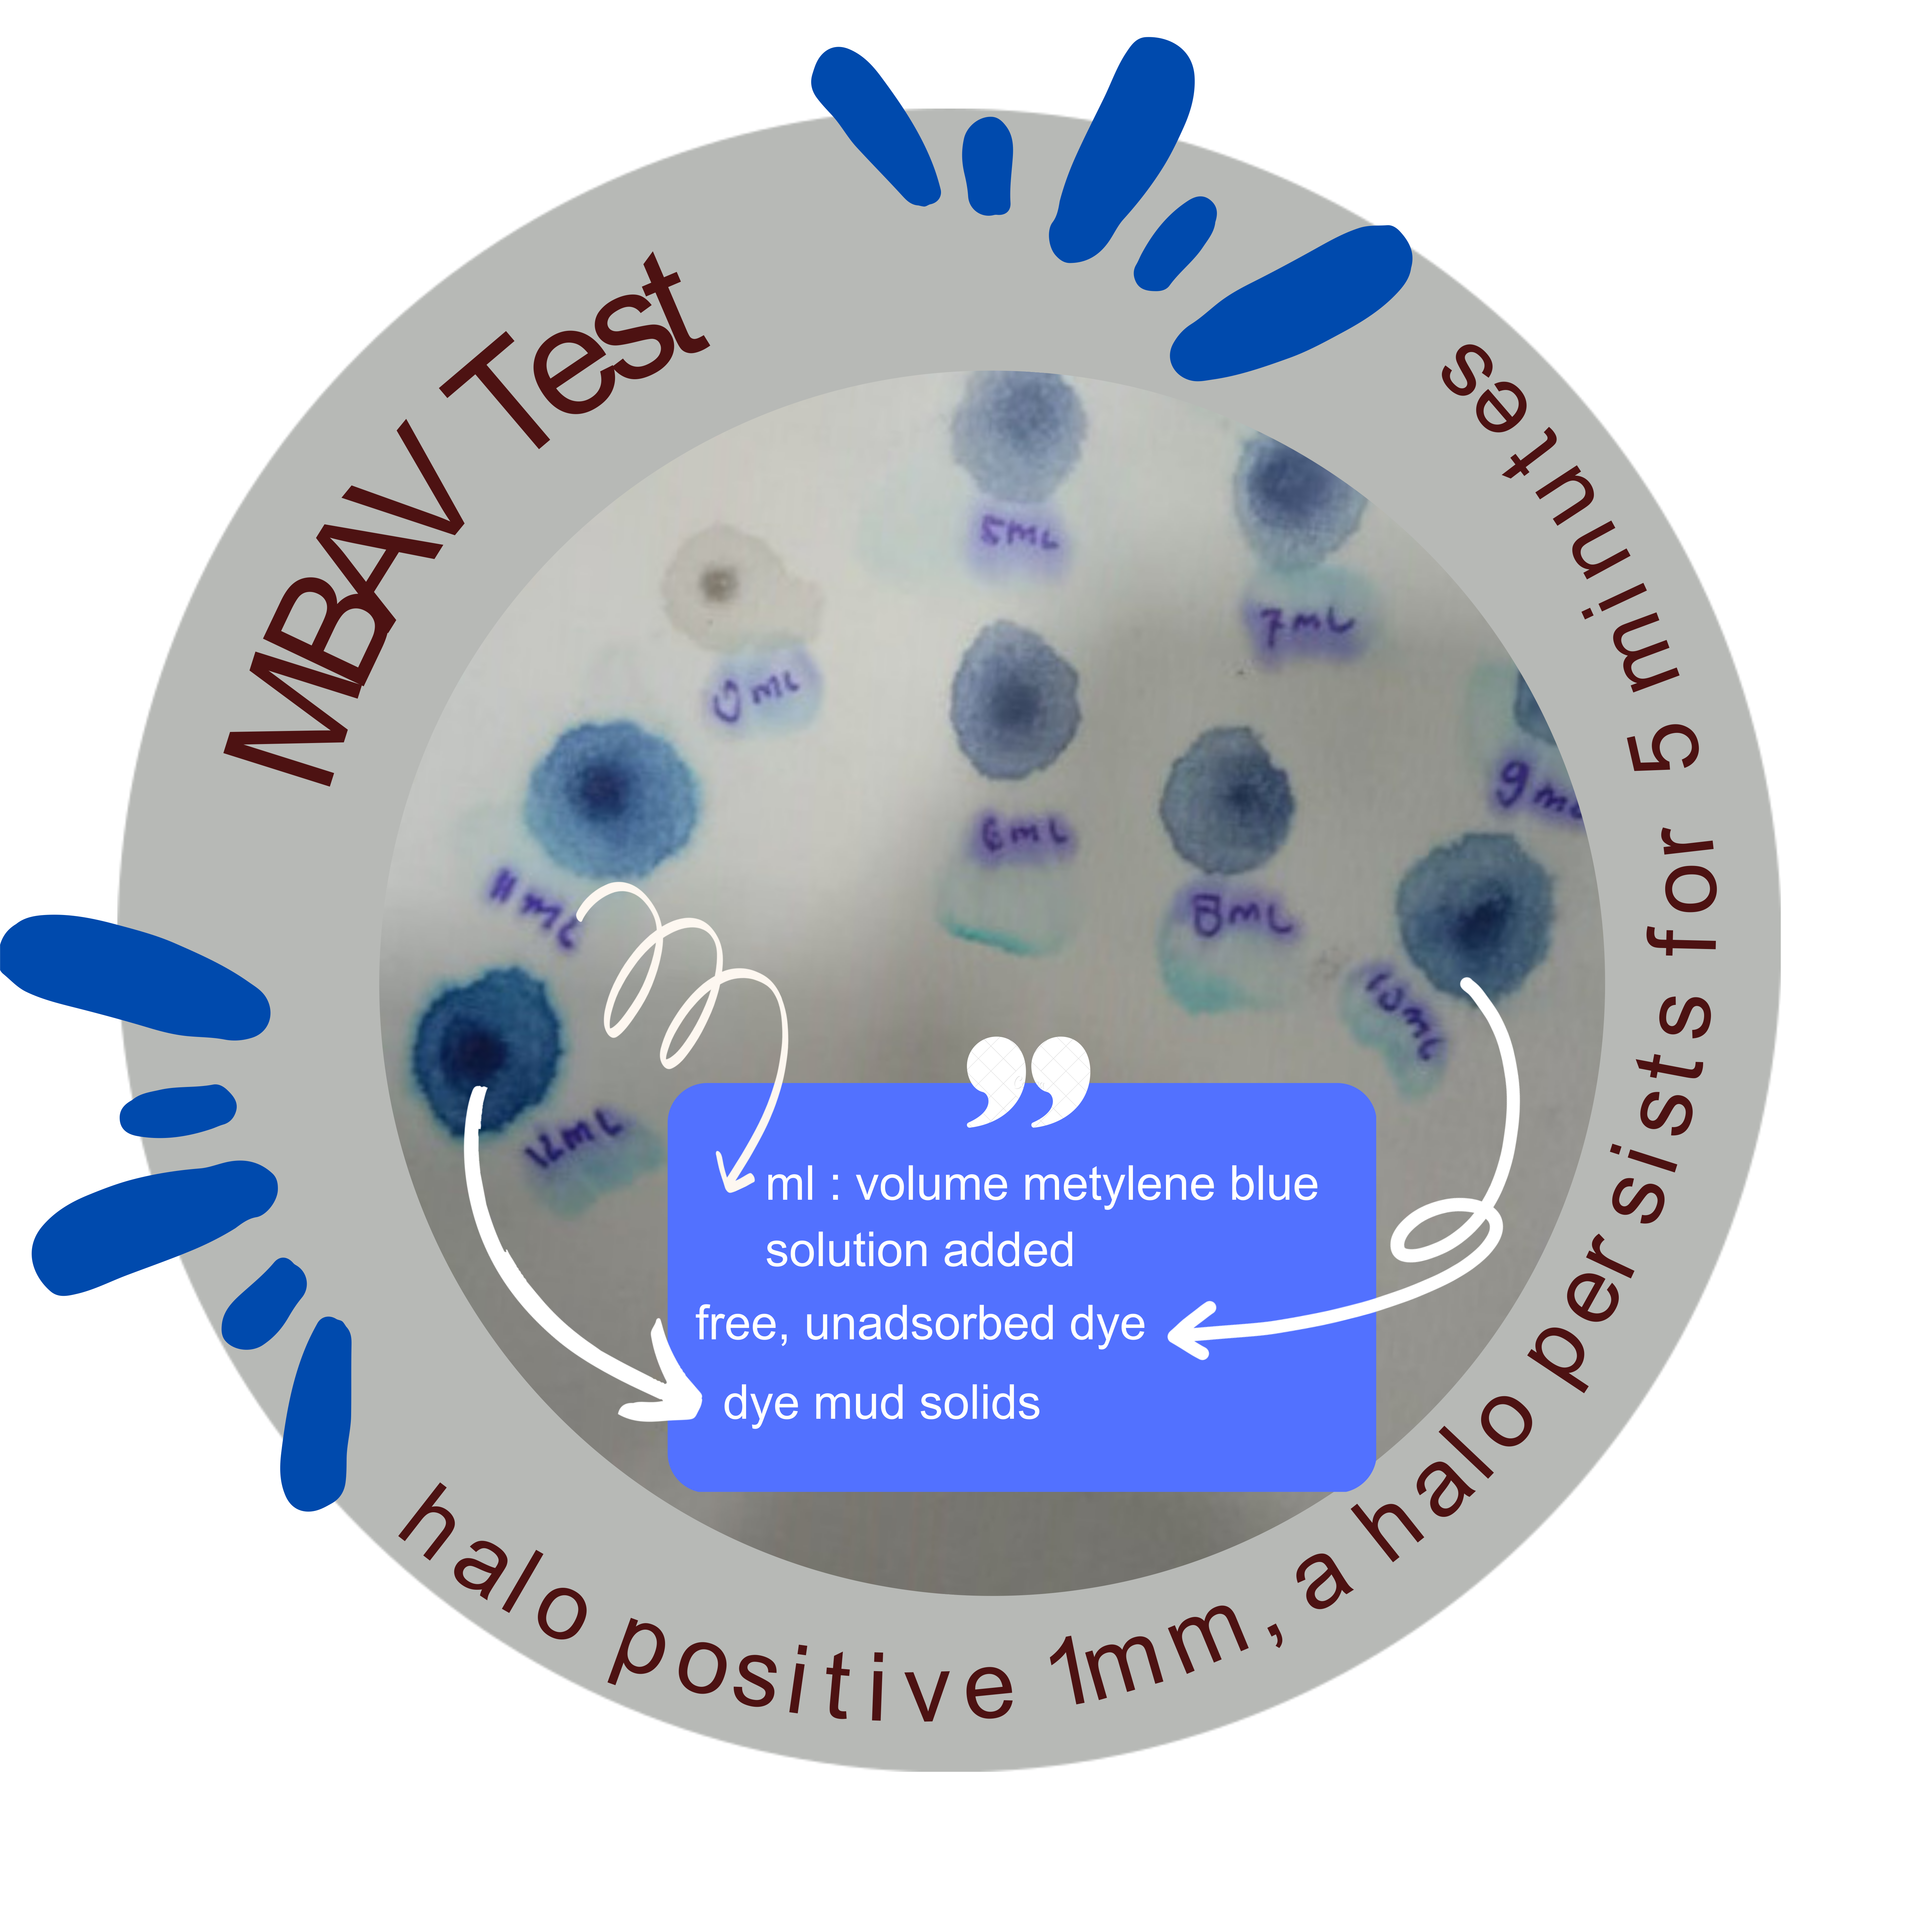

Methylene Blue Adsorption Test
Methylene blue adsorption test is a reliable and simple method to obtain information on the presence and properties of clay minerals in soils and rocks, especially in the first stages of research. If a significant amount of methylene blue is adsorbed by the soil or ground rock material, this may indicate the presence of swelling clay minerals, although there exist other substances that also may adsorb methylene blue (Verhoef, 1992). Low values of adsorption generally indicate low swelling activity (Stapel and Verhoef, 1989). In other words, low values reveal the presence of either very low amount of swelling clay or certain amount of non-swelling clay.
The spot method is a simplified titration technique. A certain concentration of methylene blue solution is added in definite volumes to a suspension of fine grained soil or ground rock particles. The total amount of methylene blue solution adsorbed is used for the calculation of methylene blue value, and cation exchange capacity (C.E.C.) of the soil or rock. The method is very simple, convenient, and quick. Therefore, it is very commonly used in engineering practice (Jones, 1964; Nevins and Weintritt, 1967; Denis et al., 1980; Steward and McCullough, 1985; Taylor, 1985; Hills and Pettifer, 1985;Bensted, 1985; Higgs, 1986; Stapel and Verhoef, 1989; Qoki;a, 1991; Verhoef, 1992). Although the test is originally developed by Jones (1964), it is improved by French scientists at Laboratoire Central des Ponts et Chaussees (LCPC). Atterberg limits, activity and C.E.C. of clays can also be expressed by Methylene Blue Adsorption (MBA) values. According to LCPC (1990 in Verhoef, 1992), MBA can also be used conveniently in soil classifications.
The methylene blue test is executed in order to determine whether the clay minerals are active and harmful. The active clay materials expand, depending on the moisture content. Methylene blue test is the only test that gives this information accurately and quickly. The test is carried out according to the EN 933-09 [4]
The purpose of this test is to determine the clay content in the fine fraction of aggregate.

